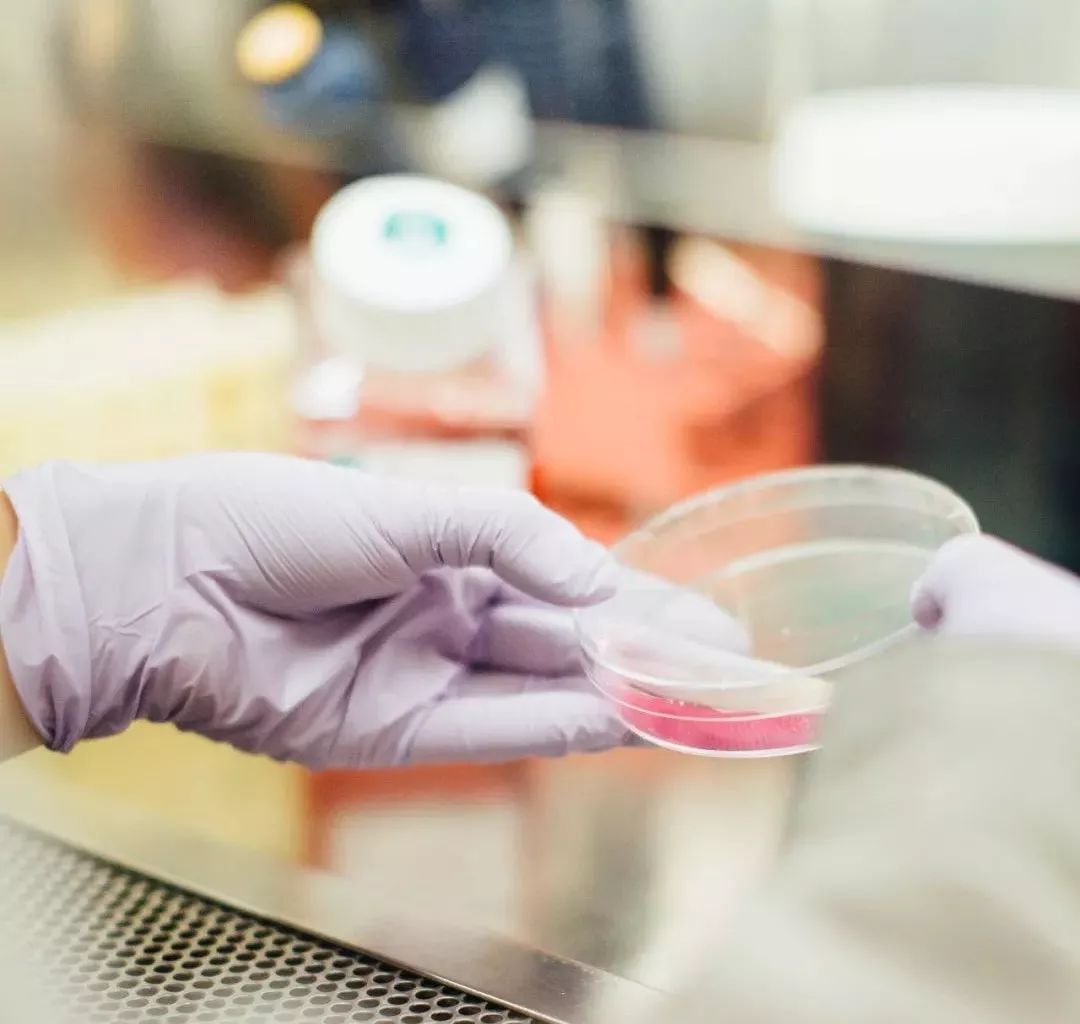
我不是药神你能保证自己不得病吗,我不是药神房子都吃没了台词

《我不是药神》上映,豆瓣评分就高达 9 分,首映第一天票房就破了 3 亿。
电影是根据真实故事改编,讲的是一个印度神油店的老板程勇(徐峥饰),从印度*私走**价格低廉的仿制药卖到国内,救了一群白血病患者的命。

《我不是药神》中的一个白血病患者吕受益。
一个落魄、油腻、有家*行暴**为的中年男人。老婆受不了他,要离婚,还要把儿子带去国外。店铺等着交租,父亲又病倒了。

所以一开始,他卖药的目的就不是救人,是赚钱。

结果他赚到了很多钱,顺便也救了很多人。

电影结束之后,很多人都是哭着听着歌,看完最后的字幕才走出影院,看过了电影,听懂了歌,才发现:活着很难,但是活着真好!
▽
“他就想活命,他有什么罪?”
但在感动之余,人们也不得不思考一个问题:如果疾病的厄运降临自己身上,该怎么面对?
影片中的病友吕受益,在影片中,吕受益是一名慢性粒细胞白血病病人,为了活命,他必须长期服用一种瑞士进口特效药“格列宁,这种药非常贵,4万块一盒,一盒只能吃一个月,算一下来,一年要吃掉48万。

他说,妻子怀孕的时候,他曾经想死,可是看到儿子后,突然有了活下去的动力,希望可以看到儿子结婚,自己当上爷爷。
然而在断药后,他的病进入了急病期。跳楼前,他回望了病床边,是一直对他不离不弃的妻子抱着儿子在简陋的小床边熟睡,他依旧结束了自己的生命。

濒临死亡的吕受益。
如果没有经历过家人生病,不会知道钱有多重要;如果没有经历过因为没钱对亲人无能为力,不会知道,钱是多么不可或缺。

网友@保佑晓飞 说,他父亲有一个同病房的病友,把家里的存款花完后,和老婆商量着把房子卖了,好继续治疗。
他老婆却直接骂他:“你不要光想自己,你也考虑考虑别人,你儿子以后要还你治病的债,再没了房子,哪个姑娘肯嫁给他?”
后来他们就默默收拾东西回家了,一个星期后,在医院见到那位叔叔的女儿,问起现状,她回答说:“我爸没了,我来办出院结算的。”
“我病了三年,房子吃没了,家人被我吃垮了”

电影里有一个患白血病的老婆婆,被周一围饰演的警察带走调查,她哭着向警察求情:“求求你们别再查了,这药假不假,病人自己能不知道吗?我得病3年,正版药吃了3年,房子吃没了,家人被我吃垮了,现在这便宜药才卖500,能救命……”
然而在电影中的警察局长看来,这药是*私走**来的,也没列入医疗手册,不是假药是什么?这里面法律与人情的冲突,唯有通过制度建设来解决。

“你就能保证一辈子不生病吗?”/ 《我不是药神》剧照
据统计,在全国约有十万分之三的白血病患者,其中儿童又占了患者的四分之一,每年新确认的白血病患者超过4万例……
对于患者来说,与医院一样可以救命的,是钱。
始终记得那个28岁的小姑娘很无奈的眼神说,“妈妈说家里已经被掏空了,治不起,不治了”!可想而知,她当时是多么的无助与恐惧。

“这世上只有一种病,穷病”
有人做过相关统计,在白血病的治疗过程中,如果治疗顺利,低危急性淋巴白血病花费一般在10-15万、中危在15万左右,高危的则需15-25万。需要骨髓移植的,就需要几十万打底了。

只是,治疗的过程很可能伴随着感染、抑制或其他并发症,因此,治疗的费用会直线上升,并且这种费用没有底线。
前述网友@保佑晓飞 的父亲刚刚确诊得了急性白血病髓系M1的时候,主治医生直接问他母亲:“治还是不治?”不治,只有两三个月可以活;治,就是不停地烧钱。
医生明确地告诉他们,“这就是个人财两空的病”。
癌症药价格高昂在研发费用之外,还有很多原因。
可以说,化疗就是花钱买命,拿不出钱来只能认命。换言之,如果每次治疗都能减少部分费用,那么患者就可以做更多疗程,也许就能把自己的生命再延长一点,甚至有治愈的希望。
因此,高额的药费加上报销比例的不同,大部分的家庭没有办法承受,但是“活着”是他们共同的目标,在救命这件事情上,他们从来不敢多想。

“药费少一点,就能活久一点”
据央视新闻报道,我国癌症发病率处于世界中等水平,但5年生存率与一些发达国家相比存在明显差距,在癌症的平均治愈率上,发达国家则达到了65%,而我国只有25%左右。
这里面的原因,首先是我国的肿瘤和癌症发现得晚,人们不到病重时不去医院检查,其次就是治疗癌症的经济成本和社会成本过高,导致普通家庭无法接受治疗,或者即使接受治疗也难以长久。

在2017年医保药品目录准入谈判中,赫赛汀、美罗华、万珂等15个疗效确切但价格较为昂贵的癌症治疗药品被纳入了医保目录。经过两轮国家医保谈判,十几种抗癌靶点药的药价已经大幅降低,并纳入医保目录。

买不起药,有些患者病急乱用药。
长期以来,癌症药品的现状概而言之就是“进口药贵,代购药悬,国产药弱”,其中最难根治的还是“国产药弱”。
《我不是药神》中的“格列宁”——原型是瑞士诺华公司生产的“格列卫”(通用名:甲磺酸伊马替尼)——在国内并不是没有仿制药,价格也不到原厂格列卫的十分之一,但原厂格列卫的销量依旧居高不下,原因就是国产仿制药的药效不如原版,甚至可能有副作用。

有的患者因为买不起进口药,也买不到有效的国产药,干脆自己从网上花120元买一个精密天平,还有胶囊壳和药物原料,亲自动手调配抗癌药。这就像“赌命”,没有人知道服用这种自制药后会出现什么反应。
好消息是,近日一款名为“昕维”的国产格列卫已经通过了国家仿制药一致性评价,是国内首个通过仿制药一致性评价的国产药。也就是说,患者终于可以买到和原厂格列卫药效一致的国产药了,价格还不到2000元。

博主@澳洲晓亮老师 透露,在澳洲有完善的医保,格列卫这个药的价格低至免费。
这是一个好的开始,
但也还没有到我们可以满意的时候。
余生漫长,除了生死,再无大事。
不祝你飞黄腾达,前程似锦,
但祝你平安、快乐、家人健康!
希望这世间少一点这样的悲剧,
希望这世间多一点爱与互助,
告诉那些白血病人,
未来很长,他不是一个人在战斗!